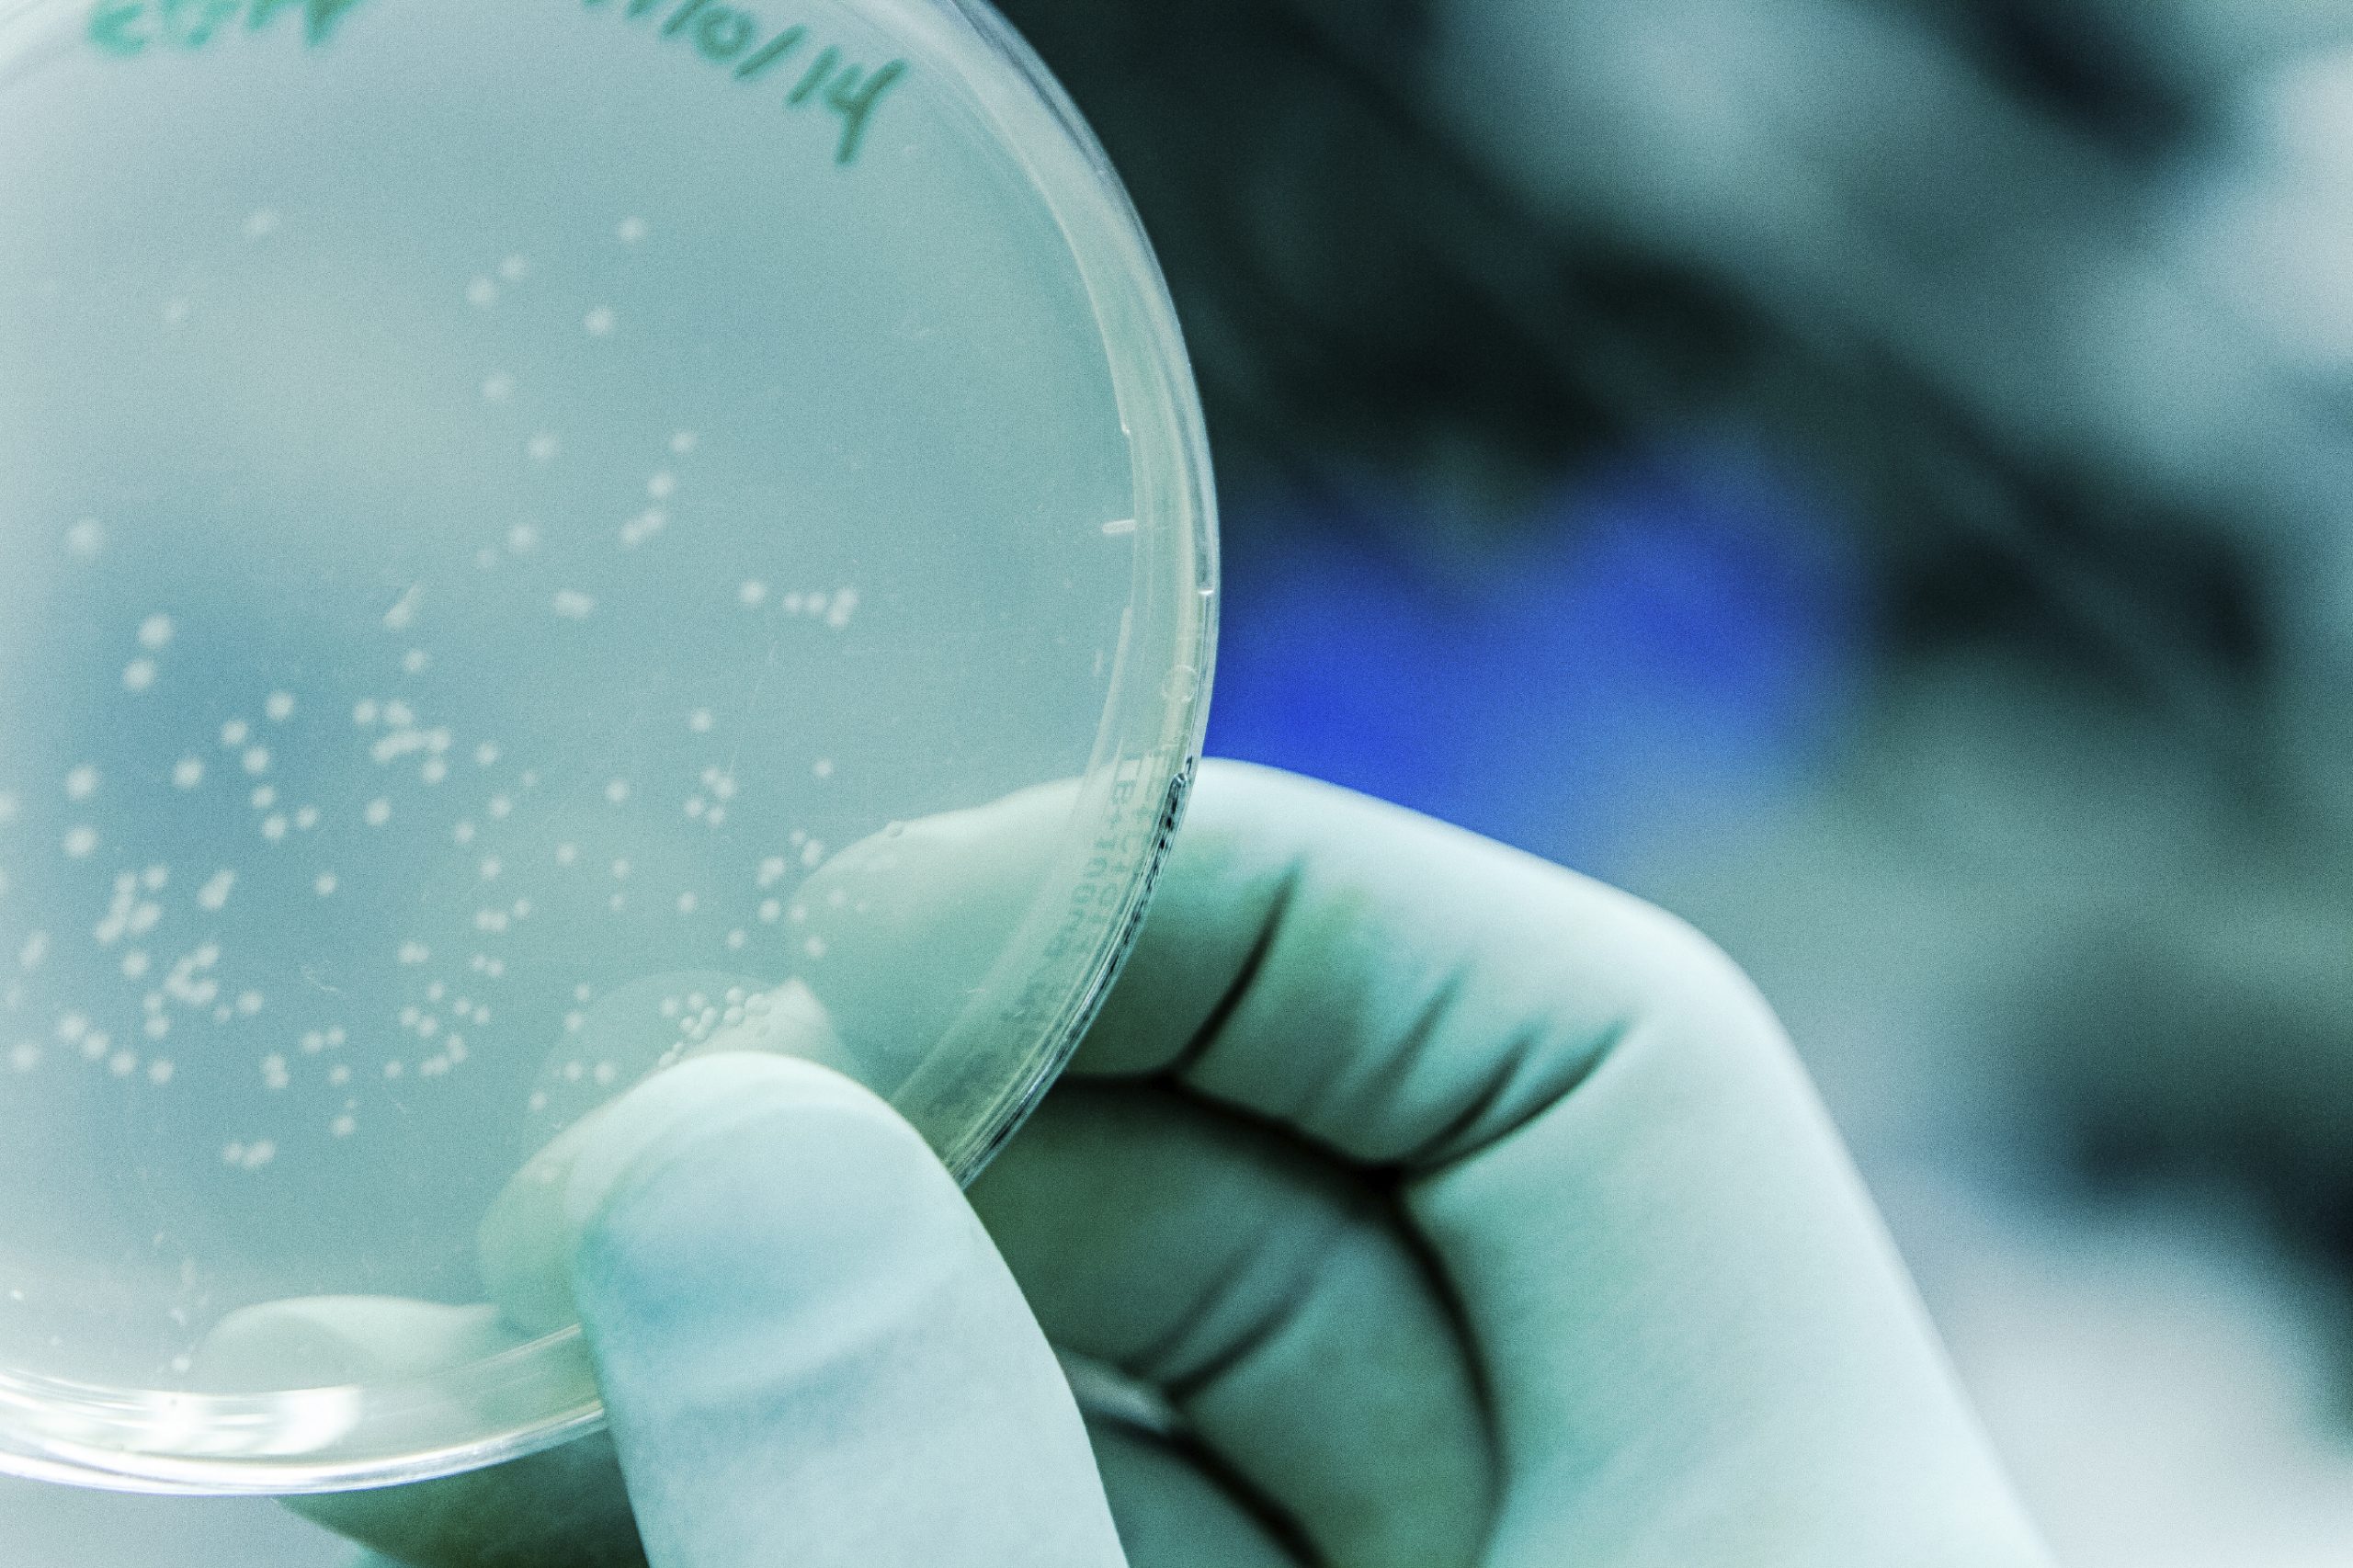
29_pma

“Drastic cuts in IVF services by the NHS should be offset by free pre-implantation genetic screening,” announced gynaecologist, Luciano Nardo, who believes that these tests“would increase couples’ chances of conception”. As far as he is concerned, this should be a “moral duty” for the NHS.
The financing of IVF sessions by the Department of Social Security in the United Kingdom has been “drastically reduced in recent months” due to cost-cutting exercises. This rationale suggests that “many sterile couples may never have children”. Doctor Luciano Nardo is therefore in favour “of increasing the chances of these couples” by proposing routine pre-implantation genetic screening. This would also allow the NHS“to cut costs by avoiding fruitless attempts”.
This PGS test[1] is regulated by the HFEA[2] and “costs approximately £535 per embryo”. It is a case of “checking the number of embryo chromosomes”. If it is abnormal, a miscarriage is more likely to occur. The doctor should therefore select a “normal” embryo “to guarantee a better IVF success rate”. Since the NHS is reducing the number of reimbursed IVF cycles, it should “make every effort to ensure that the cycle works,” added the gynaecologist.
[1] Pre-implantation Genetic Screening
[2] Human Fertilisation Embryology Authority
Daily Mail, Stephen Matthews (22/04/2017)